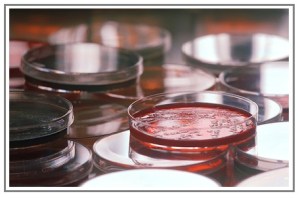
agar plates

On looking back, the signs had been there for years. First, Nadia had trouble at night from the glare. Then reading got harder, especially the day she picked up an Egyptian newspaper in Paddington. Arabic, with its tiny script and its proliferation of vital dots above and below the letters, is the least appropriate language for someone with poor vision.

She wonders why she’d got cataracts by the age of 55. Probably to do with a stupid game they used to play at the beach in Alexandria. She, Zeinab, Chou-Chou, and of course her sister Simone all dared one another to look straight into the sun for as long as they could. Nadia still has the memory of the after-burn. How was she to know, until Simone told her, that her school friends all cheated by shutting their eyes when she wasn’t looking at them?
“The Nile has cataracts too,” says Chou-Chou. She is still stupid despite being middle-aged now.
“They’re not the same thing,” Nadia replies loftily, even though she is unsure of the difference.

Nobody gets a bed on this day surgery unit. They get an armchair, but only if there’s one free at the appointed time. There isn’t. Along with three other patients, Nadia sits in the corridor. Waiting in corridors is normal in the NHS. It was never like this in Egypt, if you could afford bakshish.
An Iranian nurse and two Irish nurses seem to run the place. Each of them asks Nadia if she is diabetic.
“I’m not diabetic.”
In a nearby office, a doctor sits with the door open. Nadia can hear her complain about the computer system. Doctors always do this.
Once Nadia is installed in her allocated chair, an Irish nurse comes in to put drops into her left eye. “Are you diabetic?”
“No.”
After two lots of eye drops, her vision is so blurred that she can no longer decipher the stream of bile about immigrants, shameless young people, and disgraced celebrities in the newspaper someone discarded.
A young doctor comes to explain the op, reeling off a long list of potential complications. “There’s a one in 1,000 chance of losing all the sight in that eye.”
Nadia recalls a handsome man at Montazah who wore tiny briefs and an eyepatch. He liked to say he’d lost an eye in a duel, though, as her sister told her later, it was really a cataract operation gone wrong. She signs the consent form, sure that things have moved on and that it won’t happen to her.
The surgery is under local while her surgeon hums snatches of an aria and asks about her family.
“There’s nobody left.” Still, Nadia cradles the hope that improved vision will help her find her lost sister.
Everything is bright with a watery blue light. A machine buzzes, and the lens fragments are washed out before a new lens is put into place. She feels nothing.
Soon he says, “All done,” and peels the plastic drape off.
“You can sit up now,” says someone else.
So many voices she doesn’t know, and her head swims when she sits up.
Once back on the ward, a nurse offers her tea and asks again if she is diabetic.
Nadia checks in the mirror that she always keeps in her handbag. There she is, a plastic shield over one eye, with two long strips of tape holding it down.

The nurse returns with tea and instructions: eye drops for the next four weeks, eye shield on at night for a week, sunglasses for a few days, and no hair-washing for five days.
Of course Nadia will wear sunglasses! If her hair is going to be filthy, she doesn’t want anyone recognizing her.
The next day, she removes the eye shield for the first time. Everything is so bright. She can see every leaf on the trees, every speck of dust on the windowsill, every wrinkle on her face. They don’t make mirrors like they used to, that’s for sure.
***
Nadia is a character from my next novel, which is set in Alexandria and London.
If you’d like to know more about cataracts, try this link from Moorfields Eye Hospital.
You may also enjoy Six Lessons from the Eye Clinic.